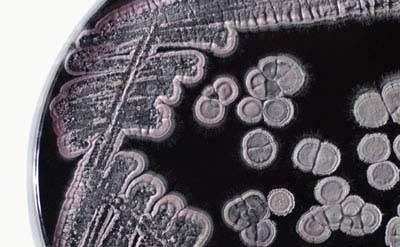

![]()
Antibióticos del Suelo y Diversidad de los Ecosistemas Forestales
Estreptomicetos. Fuente Harvard Magazine
In memorian de Luis Recatalá Boix, profesor del Departamento de Biología Vegetal de la Universidad de Valencia y miembro del CIDE-CSIC, pero sobre todo un gran profesional y buena persona (que es lo que realmente importa)
La producción de diversos antibióticos por las bacterias del suelo pueden ser uno de los factores que regulan la diversidad y composición de los ecosistemas forestales tropicales. Esta es la principal conclusión que se desprende de la noticia científica que os ofrecemos hoy, si bien la investigación llevada a cabo se circunscribe al grupo de los estreptomicetos. De acuerdo al estudio…
Los estreptomices dan cuenta de diversas bacterias del suelo muy conocidas por su prolífica producción de antibióticos. Los antibióticos pueden inhibir el crecimiento de diversos patógenos de las plantas que habitan en el medio edáfico. Las bacterias productoras de antibióticos en el suelo son la fuente de muchos de los antibióticos utilizados para combatir infecciones en los seres humanos y las plantas. Sorprendentemente, poco es lo que se sabe acerca de cómo estos microorganismos afectan a las comunidades y los ecosistemas tropicales, donde la diversidad de plantas, se enfrentan tanto a las presiones de la competencia interespecífica y de los patógenos que las infectan.
El estudio publicado el 28 de octubre en la revista Biotropica representa un paso adelante para una mejor comprensión de la función que desempeñan las bacterias y los antibióticos que las producen en la ecología de los bosques tropicales. Investigadores de la Universidad de Minnesota, encontraron que la producción de antibióticos por bacterias del suelo estaba muy extendida, pero que la abundancia y la actividad de los microorganismos variaban en el paisaje, dependiendo, en parte, de la disponibilidad de nutrientes.
Los resultados obtenidos sugieren diferencias sustanciales en las capacidades de las comunidades microbianas con vistas a suprimir las enfermedades transmitidas en los suelos de los bosques tropicales (…) aunque todo apunta a que estos productos antimicrobianos pueden estar influyendo en la diversidad de los bosques comentados.
Las diferencias en las capacidades de las comunidades microbianas para suprimir las enfermedades transmitidas a través del medio edáfico en los bosques tropicales podría afectar la propia composición florística de estas selvas. Se sospecha que los antibióticos actúan como armas que permiten a ciertas especies microbianas a aniquilar a sus competidores, incluidos los que atesoran un potencial patogénico para el mundo vegetal. Tal proceso puede conducir a la disminución de las poblaciones de los patógenos de las plantas e incluso llegar a producir lo que se denominan suelos supresivos, en los que tales enfermedades no prosperan. Debido a que diferentes plantas son susceptibles a distintos patógenos y enfermedades, la variación en la abundancia, eficacia y especificidad de los antibióticos microbianos secretados adquieren el potencial de afectar, no sólo a las enfermedades vegetales, y como corolario a su correspondiente productividad, sino también a la propia composición de las especies de arbóreas de los bosques. «Este estudio puede considerarse un primer paso a la hora de abrir un camino que nos permita entender el papel de las microorganismos en los suelos forestales tropicales (…)
Y yo me pregunto: ¿Y por qué no en otro tipo de ecosistemas?. Abajo os dejo la noticia original en Suajili.
Juan José Ibáñez
Variation in antibiotic bacteria in tropical forest soils may play a role in diversity
Date: October 28, 2014; Source: University of Minnesota
Summary: Variation in antibiotic-producing microbes in tropical forest soils has been discovered by scientists, who not that this research represents a step toward better understanding of the role they play in diversity.
Share Thishttp://www.sciencedaily.com/releases/2014/10/141028082642.htm
Streptomyces are diverse soil bacteria known for their prolific production of antibiotics. Antibiotics can inhibit the growth of diverse plant pathogens in soil. Each clear area is the “kill zone” of an antibiotic-producing Streptomyces colony against the specified pathogen target, which has been spread over the surface of the growth medium
Streptomyces are diverse soil bacteria known for their prolific production of antibiotics. Antibiotics can inhibit the growth of diverse plant pathogens in soil. Each clear area is the “kill zone” of an antibiotic-producing Streptomyces colony (which can be seen in the center) against the specified pathogen target, which has been spread over the surface of the growth medium.
Antibiotic-producing bacteria in soil are the source of many antibiotics used to combat diseases in humans and plants. But, surprisingly little is known about how these microbes impact tropical plant communities and ecosystems, where plant diversity, competition, and pathogen pressures are high.
A study published October 28 in the journal Biotropica represents a step toward a better understanding of the role antibiotic-bacteria play in the ecology of tropical forests. University of Minnesota researchers, led by Kristen Becklund, found that antibiotic production by soil bacteria was widespread, but that the abundance and activity of the microbes varied across the landscape depending, in part, on nutrient availability.
«Our results suggest substantial differences in the capacities of microbial communities to suppress soil-borne diseases in tropical forests,» says Becklund. «The fact that we are seeing all this variation is exciting because it means that these bacteria may be influencing diversity in tropical forests.»
Differences in the capacities of microbial communities to suppress soil-borne diseases in tropical forests could impact the composition of the forest itself. Antibiotics in soil are believed to act as weapons that allow microbes to kill their competitors, including pathogens. This antibiotic inhibition can lead to declines in populations of plant pathogens and can even result in the development of disease-suppressive soils. Because different plants are susceptible to different pathogens and diseases, variation in the abundance, effectiveness and specificity of microbially-produced antibiotics has the potential to influence not only plant disease and productivity, but also the composition of tree species in the forest.
«This study is an initial first step to open the black box of microbial community function in tropical forest soils,» says Powers.
Future studies will focus on the causes of the variation in density and activity and the potential consequences for tropical forest communities.
Story Source:The above story is based on materials provided by University of Minnesota. Note: Materials may be edited for content and length.
Cite This Page: MLA, APA, Chicago
University of Minnesota. «Variation in antibiotic bacteria in tropical forest soils may play a role in diversity.» ScienceDaily. ScienceDaily, 28 October 2014. <www.sciencedaily.com/releases/2014/10/141028082642.htm>.
Related Articles: Soil science, Biodiversity, Origin of life, Old growth forest, Heritability, Forest
Interesante post una vez más. Da alguna pauta para entender el problema que supone para la platanera el Fusarium oxysporun f. sp. cubense (Mal de Panamá), que se comporta caprichosamente en nuestros suelos quizá no tanto en fución de las condiciones climáticas sino de la biodiversidad edáfica propia de cada finca…
Gracias!
Dissenyar ecosistemes a partir dels bacteris del sòl…
Estic content de veure que estàs a peu de canó.
Moltes gràcies pel teu bloc !
Salut i bon estiu !
moltes gràcies per les teves paraules i els meus millors desitjos per a tu.
Una salutació cordial
Juanjo